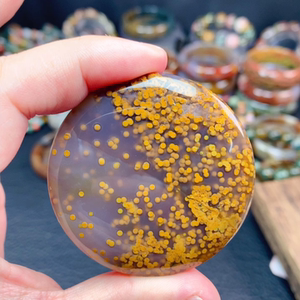
海洋碧玉老料极品圆牌

海洋碧玉

海洋碧玉
图片尺寸1080x1440
海洋碧玉球
图片尺寸720x1280
天然海洋碧玉球球
图片尺寸1080x1439
纯天然马达加斯加海洋碧玉原石球摆件
图片尺寸1080x1439
海洋碧玉,一秒穿越欧洲田园.据说最早的海洋碧玉砂矿是在194 - 抖音
图片尺寸1170x1216
天然海洋碧玉女手镯宝石收藏级水草玛瑙圈口60.2过年送礼一件代发
图片尺寸1280x1280
天然海洋碧玉水晶球手镯多彩海洋碧玉水晶愈合手镯
图片尺寸720x1280
马达加斯加海洋碧玉
图片尺寸1080x1439
海洋碧玉手镯马达加斯加ocean jasper玛瑙海洋石精品老料手圈手饰
图片尺寸750x752
天然海洋碧玉手摆件
图片尺寸1080x1439
天然海洋碧玉手镯 吊坠 手链 尺寸大小都有 品质漂亮
图片尺寸1920x1920
海洋碧玉老矿料同心圆大眼
图片尺寸1080x1080
海洋碧玉保留款手串
图片尺寸1080x1080
海洋碧玉老料极品圆牌
图片尺寸300x300
批发天然抛光海洋碧玉宝石石英晶体 palmstone 出售 - buy ocean
图片尺寸640x640
败家新品海洋碧玉
图片尺寸1080x1439
天然海洋碧玉玛瑙玉髓油画风复古文艺手镯女
图片尺寸3024x3024
海洋碧玉老矿
图片尺寸1080x1080
马达加斯加海洋碧玉
图片尺寸1080x1439
海洋碧玉水胆纹
图片尺寸1080x1439